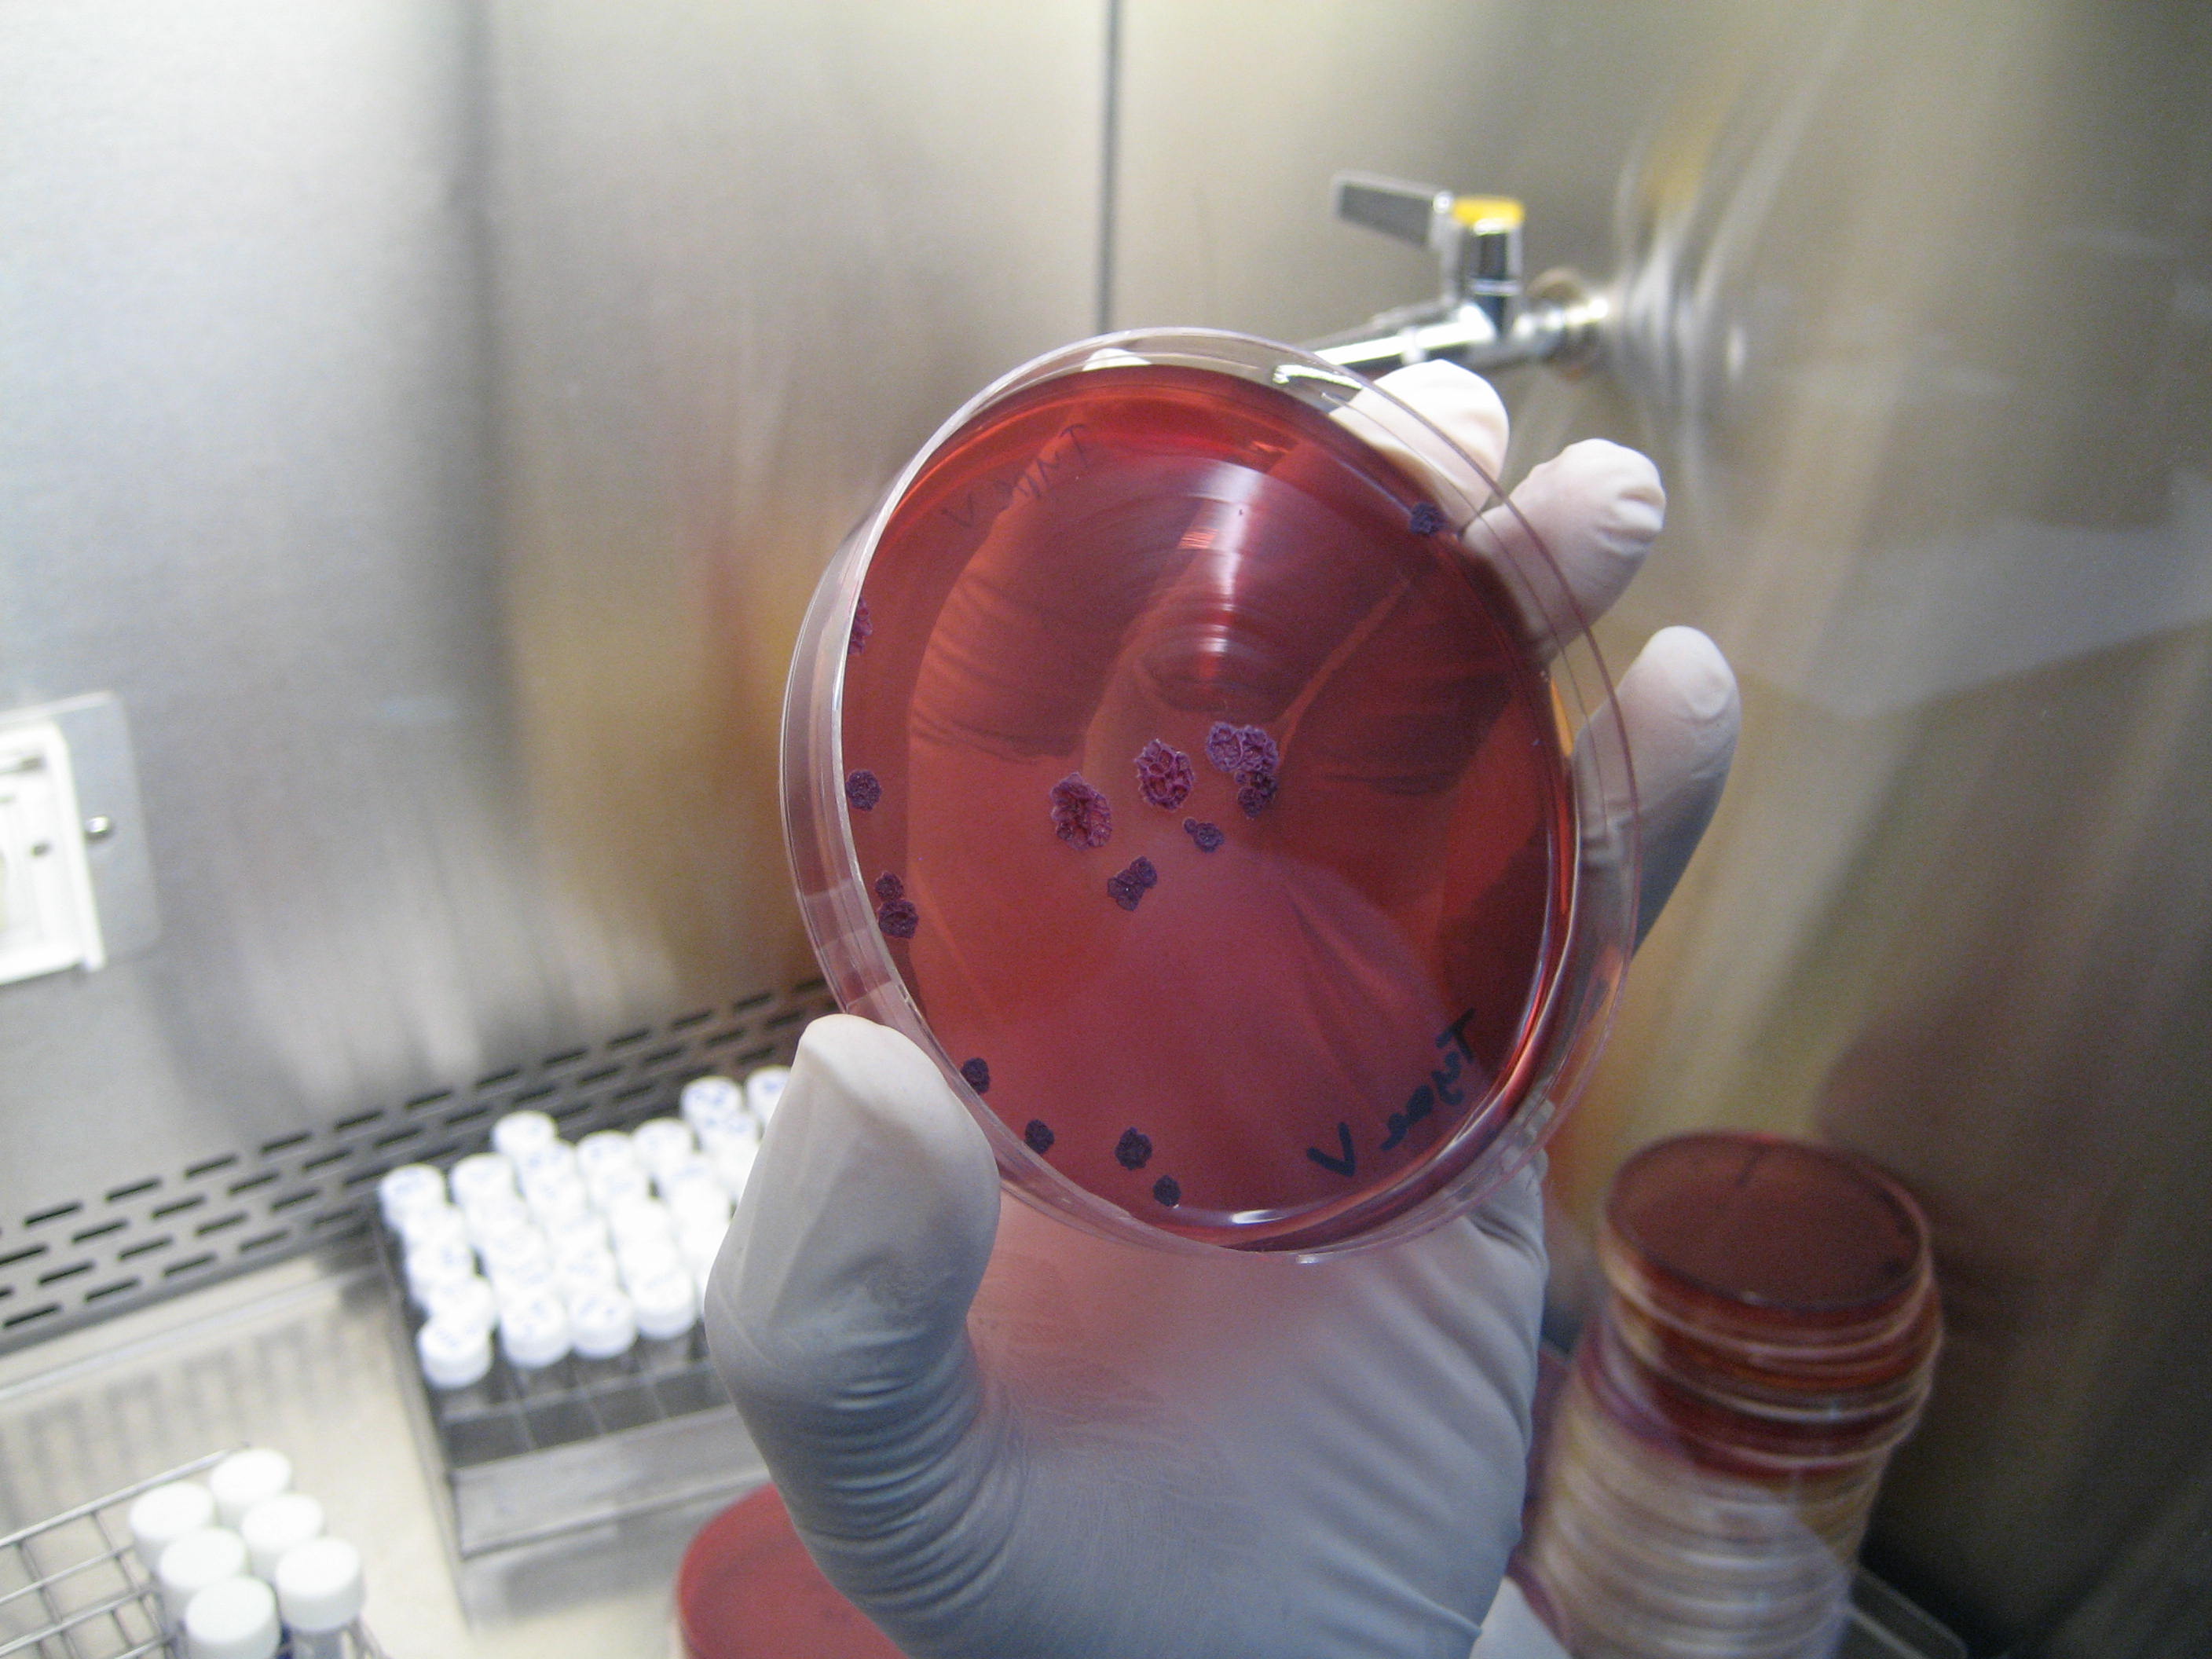
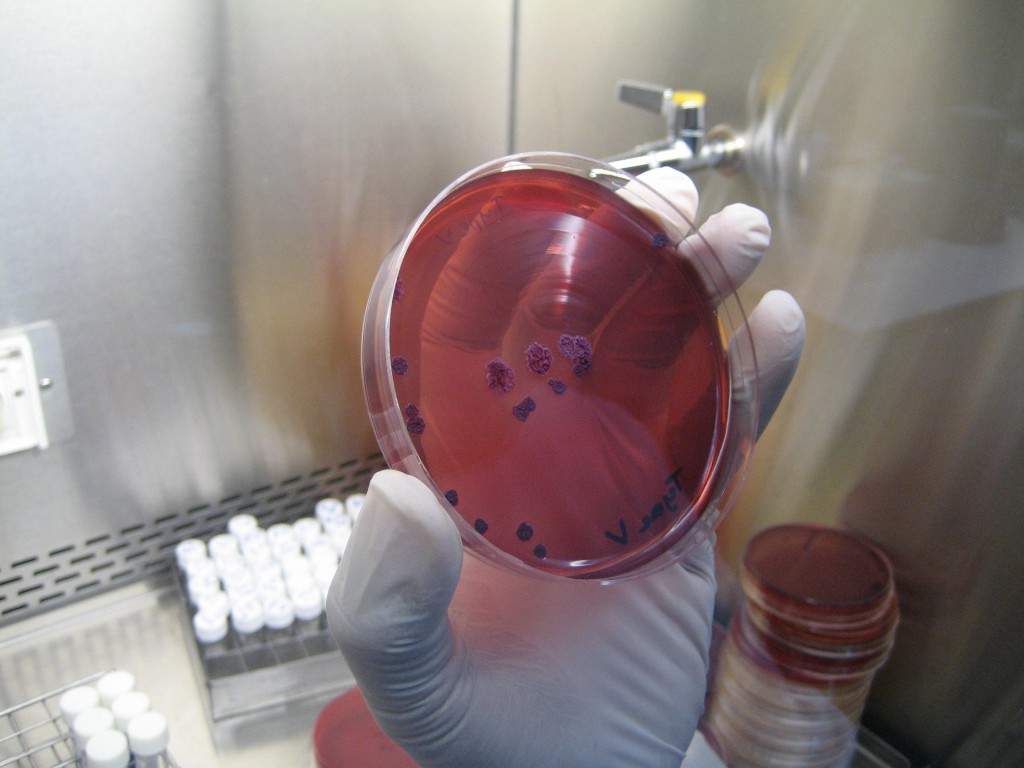

Tod aus dem Labor?
Das tödliche Bakterium Burkholderia Pseudomallei in einer Petrischale
Ein Film von John A. Kantara
Erstausstrahlung:
01.09.2008, um 21.30 Uhr
Wiederholung:
07.09.2008, um 16.00 Uhr
Notiz von Kantara´s Küchentisch….
Tod aus dem Labor?
Sieben Jahre ist es her, dass eine Anschlagserie fünf Menschen tötete, 17 verletzte und ungleich mehr Menschen in Angst und Schrecken versetzte: Todbringende Bakterien, die die Infektionskrankheit Anthrax, auch Milzbrand genannt, hervorrufen, wurden in normalen Briefen, mit der normalen Post an Journalisten und Regierungsbeamte verschickt. Der Bio-Kampfstoff kam heimlich, unverhofft und hinterhältig zu seinen Opfern.
Anfang August 2008 hat die US-Justiz in einer Indizienkette einen Angestellten eines Forschungslabors, das im Dienste der US-Regierung stand, als „einzig Verantwortlichen“ festgestellt.
Durch Militärforschung für Bio-Kampfstoffe und deren Abwehr sind in solchen Laboren gefährlichere, künstliche Varianten bekannter Erreger entstanden. Viele dieser Experimente an solchen „Menschenkillern“ sind normale Versuche an amerikanischen und europäischen Universitäten. Denn, so das Argument, der Rechtsstaat müsse sich vor potenziellen Bio-Gefahren schützen. Doch seit den Anschlägen vor sieben Jahren hat es weltweit keinen weiteren Terrorangriff mit Bio-Waffen gegeben: Alles also nur Panikmache? Erst durch Forschung für Bio-Kampfstoffe und deren Abwehr sind in den Laboren gefährlichere Varianten bekannter Erreger entstanden.
Gefahrenabwehr oder Terrorpotential
Viele dieser Experimente sind „normale“ Versuche an amerikanischen und europäischen Universitäten. Denn, so das Argument, der Rechtsstaat müsse sich vor potenziellen Bio-Gefahren schützen. Doch seit dem Anschlag hat es weltweit keinen weiteren Terrorangriff mit Bio-Waffen gegeben. Alles nur Panikmache? Ist diese Art der Forschung legitim oder schafft sie die Gefahr, die sie zu bekämpfen vorgibt?
Gefährliche Milzbranderreger
2001 wurde der 63-jährige Journalist Bob Stevens aus Florida getötet, weil er einen Brief mit Milzbranderregern (Anthrax) öffnete. Außer Stevens wurden durch die Anschläge im September und Oktober 2001 noch vier weitere Menschen durch Anthrax-Briefe getötet.
Ari Fleischer, ehemaliger US-Pressesprecher:
„Alles deutet darauf hin, dass die Milzbrandbakterien aus amerikanischen Labors kommen. Das FBI ermittelt weiter. Mehr kann ich nicht sagen.“
Auch das Kapitol in Washington DC, das Herz der amerikanischen Supermacht, wird zum Ziel der Bio-Terroristen. Noch immer stellt man sich hier die Frage, ob es ein Wissenschaftler mit Zugang zu amerikanischen Biowaffen war, der den Anschlag verübt hat. Seit den Bio-Terroranschlägen von 2001 investiert Amerika kräftig in die Forschung. Mehr als 50 Mrd. Dollar wurden bereits für den Schutz vor biologischen Bedrohungen ausgegeben. Doch haben Wissenschaftler nicht die Büchse der Pandora schon längst selbst geöffnet?
Viele Gedankenschmieden in dieser Stadt haben die möglichen Konsequenzen überdacht. Gerald Epstein ist Bio-Terrorismusexperte am Zentrum für strategische Studien CSIS:
Gerald Epstein, Bio-Terrorismusexperte:
„Die Milzbrand-Anschläge vom Oktober 2001 haben bewiesen, dass es jemanden gibt, der zu solch einer Tat fähig ist. Der Milzbrand könnte von einem Forscher oder Wissenschaftler in Umlauf gebracht worden sein. Es könnte sogar jemand mit Zugang zu unseren eigenen militärischen Vorräten gewesen sein. Das sagt uns nichts über den nächsten Bio-Terror Anschlag. In den USA haben wir den Zugang zu Milzbrand deutlich erschwert. Und ich denke, wir müssen sicherstellen, dass wir es Terroristen nicht zu einfach machen, an solche Substanzen zu kommen.“
Das FBI hat bis heute keinen Täter überführt, der letzte Verdächtige hat sich ohne Schuldeingeständnis selbst getötet. Dafür sind alle Antennen auf den nächsten Anschlag ausgerichtet. Amerika will nie wieder unvorbereitet sein.
Jeff Muller, FBI Agent: (Link zum Video, 3sat-Mediathek, 11.min.)
„Wir betrachten die biologische Bedrohung als sehr real. Seit 2006 wissen wir sicher, dass es einen kontinuierlichen Aufruf – eine Fatwa gibt, die Wissenschaftler und Ingenieure dazu bewegen soll, sich dem Djihad anzuschließen. So sollen zum Beispiel amerikanische Militärbasen als experimentelle Ziele für einen Angriff mit einer biologischen Waffe oder einer schmutzigen Bombe genutzt werden. Das ist eine sehr reale Bedrohung, die Terroristen ständig weiter entwickeln. Wir beobachten ihre Webseiten und Geheimdienstberichte, um einzuschätzen, wohin sich die Bedrohung richtet.“
Die Aufmerksamkeit der Sicherheitsexperten richtet sich bereits auf den Zugang zu Fachwissen. Ist der zukünftige Täter ein Wissenschaftler mit politischer Ambition oder ein Terrorist mit wissenschaftlicher Bildung?
Gerald Epstein, Bio-Terrorismusexperte:
„Ein Biologe, der zum Terroristen wird, erschreckt mich mehr, als ein Terrorist, der Biologe werden möchte. Wenn man in die Zukunft blickt, dann werden wir überall auf der Welt mehr Menschen haben, die sich mit Biologie auskennen. Bleibt die Frage, ob jemand dieser Menschen sein Wissen missbrauchen wird. Dieser Gedanke beunruhigt mich.“
Die tödlichsten Erreger und Gifte, die die Menschheit kennt, stehen auf der „Bio-Gefahrenliste der Amerikaner“. Können Terroristen denn an solche Erreger herankommen? Und wenn ja, wie leicht?
Meliodose – eine tickende Zeitbombe
Das Bodenbakterium Burkholderia Pseudomallei verursacht Meliodose, eine Krankheit die schwer zu erkennen ist und für die Opfer meist tödlich endet. Durch die Erreger sterben jedes Jahr an die 900 Reisbauern, allein in Thailand. Weil das Bakterium eingeatmet wird oder Menschen sich über kleine Risse in der Haut infizieren, gelten die Erreger unter Experten als ideale Bio-Waffe.
Wenn in der Regenzeit die Aussaat auf den Reisfeldern ansteht, steigen die Infektionsraten dramatisch. Das tödliche Bakterium wird aus der Erde geschwemmt. Ein Haar misst beispielsweise einen hundertstel Millimeter. Die Welt der Bakterien beginnt bereits bei einem Tausendstel Millimeter und die der Viren sogar bei einem Zehntausendstel. Der Feind bleibt unsichtbar.
Der Bio-Waffenexperte Jan van Aken arbeitet für das Sunshine Projekt, einer kleinen Nichtregierungsorganisation und berichtet seit Jahren kritisch über den Graubereich biologischer Forschung. In Thailand ist Dr. van Aken auf der Spur von Burkholderia Pseudomallei, denn das Bakterium scheint Bio-Terroristen und Tropenmediziner gleichermaßen brennend zu interessieren.
Dr. Jan van Aken, Bio-Waffenexperte:
Hier in Thailand gibt es eine Krankheit, die gerade hier in der Gegend um Ubon Rachanthani sehr häufig vorkommt, das ist die sogenannte Meliodose. Der Erreger dahinter nennt sich Burkholderia Pseudomallei. Den gibt es bei uns in Europa nicht, deswegen haben wir in Deutschland eigentlich nie etwas mit dieser Krankheit zu tun. Er ist aber von verschiedenen Ländern in den letzten Jahrzehnten auch als Bio-Waffe entwickelt worden. Wir wissen das von den Japanern im Zweiten Weltkrieg. Und nach dem Krieg haben es die Sowjetunion und die Amerikaner intensiv untersucht, ob es sich als Bio-Waffe eignet. Und ja, es eignet sich, denn man kann es über die Luft ausbringen, Menschen können es einatmen, sich infizieren und deswegen gilt es als eines der wenigen Krankheitserreger, die wirklich als Waffe auch eingesetzt werden können.“
Am Sapasitthiprasong Regionalkrankenhaus von Ubon Rachanthani werden die meisten Burkholderia Pseudomallei-Opfer behandelt. Jan van Aken besucht hier Kae Wirongrong Chierakul. Die Wissenschaftlerin der Mahidol Universität aus Bangkok erforscht hier zusammen mit Kollegen der britischen Oxford Universität seit zwanzig Jahren den Erreger der Meliodose.
In seiner schlimmsten Form tötet Burkholderia Pseudomallei die meisten seiner Opfer innerhalb weniger Tage. Es vergiftet das Blut und greift Lunge, Herz und Nieren an. Doch bei manchen Patienten kann sich das Bakterium über Jahrzehnte unentdeckt im Körper verstecken, ohne dass eine Krankheit ausbricht – warum ist völlig unklar.
John A. Kantara besucht die Intensivstation
Dr. Jan van Aken, Bio-Waffenexperte:
„Das Gefährlichste an der Meliodose ist eigentlich die hohe Todesrate. Wenn man an dem Erreger erkrankt, hat man in der Regel nur eine 50 prozentige Überlebenschance. Die Angst vor dem Bio-Terrorismus ist die Erkenntnis, dass Bio-Waffen vor allem eine Terrorwaffe sind. Weil sie Angst erzeugen, selbst wenn am Ende kaum jemand stirbt, erzeugt es eine weltweite Panik, verursacht Kosten in Milliardenhöhe, kann teilweise auch Gesellschaften durcheinander bringen für einige Zeit, das ist die größere Gefahr bei den Bio-Waffen, als der tatsächliche Schaden vor Ort.“
Bricht Meliodose aus, zeigt sich oft eine Kombination verschiedenster Symptome, die vollkommen unterschiedlichen Krankheiten zuzuordnen sind. In Europa haben Ärzte kaum Erfahrung mit dieser Krankheit. Weil die Behandlung Monate dauert, wäre eine Masseninfektion in Deutschland sehr teuer und nur schwer zu beherrschen.
Das Interesse der amerikanischen Biogefahrenabwehr ist groß. Die Forschungsarbeiten der thailändischen Wissenschaftler werden vom US-Militär genau beobachtet. Immer öfter bekommen sie Besuch aus Amerika. Bisher haben Amerikaner kein Geld in diese Krankheitsbekämpfung gesteckt. Doch aufgrund der vorhandenen vermeintlichen Bio-Gefahr tun sie es nun.
Dr. Kae Wirongrong Chierakul, Wissenschaftlerin:
„Nun, was auch immer sie hierher bringt, wenn das Endergebnis eine Verbesserung für die Patienten ist, wenn wir das Wissen über diese Krankheit verbessern, sie besser kontrollieren können, dann ist es eine gute Sache.“
Selbst wenn die Patienten überleben, müssen sie ihr Leben lang unter Beobachtung bleiben. Die Gefahr, dass das Bakterium als Waffe missbraucht wird, ist immer noch sehr groß. Das wissen auch die Experten der Biogefahrenabwehr. Vanaporn Wuthiekanun hat einen Schnelltest entwickelt, der eindeutig ist und deshalb schon vielen Menschen das Leben gerettet hat.
In ihrem Labor lagern die hochinfektiösen Proben und Abstriche von Tausenden Meliodose-Opfern. Und ihr ist klar: Die Todesrate liegt immer noch bei 50 Prozent. Hinter jeder Petrischale verbirgt sich ein Opfer.
Hohe Sicherheitsstandards im Labor
Im Labor hat sich noch nie jemand mit Meliodose infiziert. Das spricht für die Sicherheitsstandards des Hospitals, die den üblichen internationalen Normen entsprechen. Meliodose wird oft mit Krebs oder Tuberkulose verwechselt. Ein tödlicher Irrtum: Denn wenn die Fehldiagnose erkannt wird, ist es oft schon zu spät.
Versteckt sich der Erreger im menschlichen Körper, kann ein Infizierter dem Bakterium auch noch nach Jahrzehnten zum Opfer fallen. Ein US-Veteran des 2. Weltkrieges erkrankte 62 Jahre nach der Infektion an Meliodose. 250.000 US-Veteranen des Vietnam-Krieges gelten als gefährdet. Wie viele von Ihnen an Meliodose sterben werden ist ungewiss.
Es muss Vorsorge getroffen werden, dass das Labor nicht selbst zur Infektionsquelle wird. Doch der Ausbruch eines hochinfektiösen Erregers aus einem vermeintlich sicheren Labor ist leider keine Seltenheit. Labore sind nie 100 prozentig sicher. Es sind etliche Beispiele bekannt, wo Erreger auch aus einem Labor ausgebrochen sind. Entweder haben sich Mitarbeiter infiziert oder, wie August 2007 im Fall England, hat in einem Labor die Sterilisation nicht geklappt und plötzlich ist in der Gegend die Maul und Klauenseuche aufgetreten. Das hätte zu einem riesigen Desaster führen können.
Dr. Jan van Aken, Bio-Waffenexperte:
„Weltweit gibt es solche Fälle. Das heißt, wir sollten möglichst wenig mit solchen Erregern forschen – nur das, was wirklich medizinisch notwendig ist. Wir sollten nur Menschen daran lassen, die es wirklich können, und am Ende hilft nichts, es kann immer wieder Fehler geben, und darauf muss man vorbereitet sein.“
Wer mit extrem gefährlichen Erregern arbeiten will, braucht ein Labor der höchsten Sicherheitsstufe. Viele davon sind veraltet. In Europa entstehen deshalb gleich sechs neue Hochsicherheitslaboratorien. Drei davon in Deutschland. Eines der größten und modernsten Labore ist gerade im Bau. Sobald die ersten Funktionstests laufen, kommt nichts und niemand mehr ohne komplette Dekontamination in den Sicherheitsbereich.
Der Ingenieur Maik Preußer hat mit seinen Kollegen alle drei neuen Hochsicherheitslabore in Deutschland entworfen. Auch International läuft das Geschäft der Kölner Ingenieure ausgezeichnet. Obwohl die Kosten pro Hochsicherheitslabor bei über 40 Millionen Euro liegen.
Maik Preußer, Ingenieur:
„Das Außergewöhnliche ist, dass das hier ein Edelstahlkäfig ist, der rundum in ein bestehendes Gebäude eingeschweißt wird. Der auch mit einer Druckprobe, die er bestehen muss, ganz klar luftdicht ausgeführt ist. Man kann hier mit jeglichem hochinfektiösen Material arbeiten. Also mit Viren oder Bakterien, das könnte Ebola oder Lassa sein, man kann damit hier bedenkenlos arbeiten. Das ist sicher.“
Spezial-Filter fangen Staub, Bakterien und Viren aus der Abluft. Zwei Filter hintereinander sind in Deutschland Vorschrift. Ihnen entgehen nicht einmal Nano-Partikel. Die Raumluft strömt konstant von den ungefährlichen zu den gefährlicheren Bereichen des Labors. Tote Winkel ohne Strömung werden bei der Einrichtung vermieden.
Maik Preußer, Ingenieur:
„Es ist wichtig, dass hier immer ein Unterdruck gehalten wird, damit von den Bakterien und Viren, mit denen gearbeitet wird, eben nichts raus kann. Wenn ich jetzt versuche eine Tür zu öffnen, dann habe ich immer einen Zug nach hier innen. Also selbst wenn wirklich mal eine Schleuse einen Spalt offen sein sollte, dann zieht eigentlich keine Luft raus, sondern nur die von außen zieht nach innen.“
Abwasser aus den Desinfektionsduschen und dem Labor wird in einen Dekontaminationstank geleitet. Unter hohem Druck wird alles eine halbe Stunde lang bei 125°C gekocht. Ähnlich wie bei den Lüftungsanlagen ist jedes Abwasserrohr und jede Pumpe doppelt vorhanden.
Nichts verlässt das Labor, ohne dekontaminiert zu werden. Technisch ist das System narrensicher – der größte Unsicherheitsfaktor bleibt der Mensch.
Die thailändischen Forscher wissen, dass in der Gegend um Ubon Ratchathani fast jeder Einwohner, ab dem Alter von vier Jahren schon mit dem Bakterium in Berührung gekommen ist und Antikörper im Blut hat.
Es gibt keinen Impfstoff, denn Antikörper schützen nicht gegen eine neuerliche Infektion. Eine Infektion überlebt man nur durch eine schnelle, präzise Diagnose, die Gabe eines Antibiotika-Cocktails und die Vermeidung einer erneuten Infektion.
Eine seltene Erfolgsgeschichte
Die drei Wissenschaflter Jan van Akten, Kae Wirongrong Chierakul und Vanaporn Wuthiekanun besuchen eine Bäuerin, die überlebt hat. Sie ist eine Erfolgsgeschichte, die nur teilweise zufriedenstellend ist. Einerseits hat sie überlebt, andererseits hat sie ihre Lebensgewohnheiten nach der Infektion wenig geändert. Die Ärzte wissen: Der direkte Kontakt des im Boden lebenden Erregers mit der Haut ist ein großes Risiko. Und die Bäuerin bleibt zweifellos eine Risiko-Patientin.
Vor drei Jahren wurde sie infiziert und hatte einen großen Abszess im Gesicht. Eine große Narbe zieht sich von ihrer Stirn bis über ihr Auge. Die größte Gefahr für eine erneute Infektion liegt darin, dass sie barfuß ist! Um sich ausreichend zu schützen, sollte sie Gummistiefel tragen. Ihr Mann macht es mit den Stiefeln richtig.
Würde das Bakterium als Waffe eingesetzt werden, steckt in den Langzeitfolgen ein enormes Terrorpotential. Da der Erreger oft erst bei einer Schwächung des Immunsystems zuschlägt, sind die Langzeitfolgen unkontrollierbar. Alle Infizierten sind bedroht. Auch wenn sie heute noch keine Symptome zeigen, könnten sie selbst zum Überträger werden.
Seit das Genom dieses erstaunlichen Killers entschlüsselt ist, versuchen Wissenschaftler, dem Bakterium mit Hilfe von neuen gentechnischen Methoden beizukommen. Aber sind diese neuen Methoden wirklich harmlos?
Dr. Jan van Aken, Bio-Waffenexperte:
„Ja, in der Burkholderia-Forschung sehe ich im Moment zwei grundlegend verschiedene Ansätze. Das eine ist das, was hier in Thailand gemacht wird, da geht´s direkt um die Patienten, da versuchen sie neue Methoden zu entwickeln, das besser zu heilen, die Todesrate zu senken, das ist an der Medizin, an den Menschen, an den Kranken orientiert.
Und dann gibt es eine zweite Art von Forschung, die zum Teil momentan in den USA auch in Militärlabors gemacht wird, da geht’s eher darum, genetisch zu analysieren, welche verschiedenen Stämme gibt es oder auch gerade jüngst eine Veröffentlichung, welche Gene machen denn Burkholderia so gefährlich?
Wenn ich das weiß, kann ich ihn damit nicht ungefährlicher machen. Und habe keine bessere Behandlung für den Menschen. Sondern diese Art von Forschung ist immer ein zweischneidiges Schwert, damit könnten sie ein noch gefährlicheres Bakterium herstellen am Ende.“
Nachbau von Erregern im Labor
Im Jahr 2002 zeigte der deutsche Wissenschaftler Prof. Eckard Wimmer wie das Poliovirus, das die Kinderlähmung hervorruft, im Labor nachgebaut werden kann. Wimmer und sein Team nutzten dazu die im Internet frei verfügbare DNA-Sequenz des hoch ansteckenden Erregers und kommerziell erhältliche DNA-Schnipsel.
„Dual-Use“ nennt die Forschergemeinde das Problem: Neue gentechnische Verfahren versprechen neue Medikamente im Kampf gegen fürchterliche Krankheiten wie SARS, AIDS, Kinderlähmung oder Meliodose. Die andere Seite der Medaille ist der Missbrauch dieser legitimen Forschung für die Herstellung von Biowaffen.
Prof. Eckard Wimmer, Wissenschaftler:
„Es gibt keine Möglichkeit, sich gegen diesen Fortschritt zu schützen. Es gibt keine Möglichkeit, Fortschritt einzudämmen. Und deshalb hat das Verteidigungsministerium der Vereinigten Staaten die Neusynthese des Virus finanziell unterstützt und sie waren sehr daran interessiert, dass die Arbeit gemacht wird.“
Es war das erste Mal, dass jemand eine DNA-Sequenz und die notwendigen Chemikalien nutzte, um daraus einen Virus nachzubauen. Die Bauanleitung der meisten Viren steht mittlerweile im Internet. Jedes Virus kann heute im Prinzip im Labor nachgebaut werden. In der nahen Zukunft könnten dies auch Kriminelle oder Terroristen versuchen. Es gibt keinen Grund mehr den Erreger mühsam in der Natur zu isolieren oder aus einem Hochsicherheitslabor zu stehlen. Der erste Schritt, die Synthetisierung eines tödlichen Erregers im Labor, ist ein realistisches Szenario. Kann das bald jeder tun?
Prof. Eckard Wimmer, Wissenschaftler:
„Die Gefahr besteht, dass ein Organismus zusammengesetzt wird aus Teilen von anderen Organismen, der nicht kontrolliert werden kann, der aus dem Labor rauskriecht und anfängt, Menschen und Städte usw. umzubringen. Wir können nicht verhindern, dass irgendwo in der Welt irgendjemand die Gelder zusammensammelt, um sich die gleichen Methoden und Instrumente anzueignen, um Missbrauch zu treiben.“
Am Helmholz-Zentrum für Infektionsforschung in Braunschweig nutzt man auch die Möglichkeiten der synthetischen Biologie. Auch hier versuchen die Wissenschaftler, Bakterien genetisch so zu verändern, dass sie zum Beispiel Umweltgifte besser abbauen können.
Bio-Informatiker verändern dazu den genetischen Code des Bakteriums am Computer. Die so veränderte DNA wird einfach bei kommerziellen Genkonstrukteuren bestellt. Die maßgeschneiderte Herstellung kompletter Genome wird professionell erledigt.
Aus DNA-Schnipseln künstlich neue Viren oder Bakterien erschaffen? Die meisten Wissenschaftler sind davon allerdings überzeugt, dass die Chancen der synthetischen Biologie die Risiken bei weitem übertreffen.
Rudi Balling leitet das Helmholzzentrum für Infektionsforschung. Für ihn sind Gene Bausteine der Natur, die es für den Menschen zu nutzen gilt. Er sieht Chancen und Risiken der neuen Gen-Revolution in der Biologie.
(Link Interview Prof. Rudi Balling)
Prof. Rudi Balling, Genetiker:
„Man kann Bakterien verändern, indem man neue Gene einbringt oder andere entfernt. Man kennt mittlerweile eine Reihe von Genen, die in manchen Bakterien vorkommen, die Dioxine oder bestimmte Umweltsubstanzen oder Schadstoffe abbauen können. Also ich statte Bakterien mit neuen Eigenschaften aus. Und dann mache ich mir schon Bakterien, Viren so zunütze, dass sie das tun, was ich will.“
Langfristig will die synthetische Biologie die Bio-Technologien radikal vereinfachen. Bakterien sollen dazu gebracht werden, Dinge zu tun, für die sie die Natur nicht vorgesehen hat. Nun hat Craig Venter, ein amerikanischer Biologe, bereits angekündigt, das erste künstliche Bakterium zu bauen und die Verfahren zu patentieren. Hybris oder geniale Zukunftsvision?
Dr. Jan van Aken, Bio-Waffenexperte:
„Die Aktivitäten des Herrn Venter machen mir Sorgen. Er hat angekündigt, wahrscheinlich noch in diesem Jahr zum ersten Mal ein komplett künstliches Bakterium zu produzieren, mit dem Ziel, dann einen richtigen Baukasten an verschiedenen Genen zu haben, die braucht man nur zusammenzustecken in diesem Bakterium und schon habe ich ein Öl fressendes Bakterium, ein CO-2 fressendes Bakterium oder ich produziere damit Rohstoffe, sozusagen, die ganze Welt wird gerettet mit diesem Bakterium. Und wenn ich diesen Satzbaukasten erst einmal habe, dann kann ich den natürlich ganz einfach für Bio-Terroristische Zwecke missbrauchen.“
Nun kommen selbst den Befürwortern dieser neuen Technologie Zweifel, ob der freie Zugang zu dieser Technik nicht zu gefährlich ist. Heute braucht es nur noch Geschick, Geduld und Geld, um einen Organismus künstlich herzustellen.
Prof. Rudi Balling, Genetiker:
„Unsere Erkenntnis, das, was wir wissen, über Mechanismen, wie Leben funktioniert, wie etwas überlebt und lebt und die Physiologie, denk ich, müssen, sollten, wollen wir teilen. Wie gehen wir mit potentiellen Anleitungen für Waffenbau um? Ich denk, hier ist die Wissenschaft durchaus bereit, auch selbst zu schauen, was sollten wir im Grunde nur den Personenkreis, den Forschungsinstitutionen den Firmen zur Verfügung stellen, die damit verantwortlich umgeht, so eine Vertrauensüberprüfung.“
Das Vertrauen in die Selbstregulation der Wissen- schaft gründet auf der Transparenz wissenschaft- licher Arbeit. Solange Forschung nicht im „Geheimen“ stattfindet, gibt es auch Kontrolle. Und: Das Szenario, wonach ein Bio-Terrorist in einer Garage einen tödlichen Erreger reproduzieren könnte, entspricht „noch“ nicht der Realität. Schon in ein paar Jahren könnte es vielleicht soweit sein.
Für die Menschen in Thailand sind diese Diskussionen weit weg. Für sie ist die Natur noch immer der größte Bio-Terrorist. Und: Die Natur hält vielleicht auch die Lösung des Problems bereit. Der Kampf einer Mikrobe gegen eine andere. Denn das hohe Ansteckungsrisiko mit Burkholderia Pseudomallei hängt eng mit der dichten Verteilung des Bakteriums im Boden zusammen.
Ein Experiment mit Bio-Dünger
Auf einem Test-Reisfeld suchen die Wissenschaftler der Mahidol-Universität nach einer biologischen Lösung, um die hohe Konzentration des gefährlichen Bakteriums im Boden zu senken. Auch auf dem Testfeld steht die Bio-Sicherheit an erste Stelle. Während der Entnahme einer Bodenprobe wird die Umgebungsluft angesaugt, um festzustellen, ob der Erreger in der Luft nachzuweisen ist.
Beobachtungen der thailändischen Wissenschaftler im Labor haben ergeben, dass die Mikroorganismen eines kommerziell erhältlichen Bio-Düngers die Konzentration des Erregers im Boden deutlich senken können. Ein Test-Reisfeld dient Vanaporn Wuthiekanun für ihr Experiment, ein anderes ist ein Kontrollfeld, das normal weiter bewirtschaftet wird.
Der Bio-Dünger beinhaltet mehr als 100 verschiedene Organismen. Einige Bakterien, Hefen und Pilze sind auch darunter. Vanaporn Wuthiekanun weiß: Im Labor konkurriert irgendetwas mit Pseudomallei um Ressourcen in der ökologischen Nische.
Auf den Feldern der Reisbauern, die den Bio-Dünger seit Jahren nutzen, konnte sie Pseudomallei nicht mehr nachweisen. Ganz im Gegensatz zu den Feldern, auf denen immer noch mit einem chemischen Dünger gearbeitet wird. Kann die Lösung wirklich so einfach sein?
Dr. Jan van Aken, Bio-Waffenexperte:
„Ja, ich finde das eine ganz phantastische Idee zu sagen, wenn dieser Erreger wirklich so gefährlich ist, dass wir ihn nicht wirklich heilen können, wenn die Menschen damit krank geworden sind, dann von vorneherein die Infektion zu verhindern. Man kann den Reisbauern nicht verbieten, in ihre Reisfelder zu gehen, aber der Versuch hier ist jetzt, dieses Bakterium aus den Feldern zu vertreiben. Und die Daten, die bis jetzt vorliegen, deuten alle in die Richtung, wenn man das drei, vier Jahre macht, ist unser Krankheitserreger verschwunden und der Bauer hat kein Problem mehr.“
Noch ist es zu früh zu sagen, ob der Versuch wirklich ein Erfolg sein wird. In den nächsten Monaten wollen die Forscher erste Ergebnisse vorliegen haben. Doch für die Menschen, die heute das Risiko tragen, Opfer von Meliodose zu werden, bedeutet jeder Versuch, etwas daran zu ändern, Hoffnung.
Die Gefahr, dass das Bakterium aus den Reisfeldern Thailands von Terroristen für Anschläge missbraucht wird, bleibt bestehen. Genau wie die Gefahr aus dem Labor. Menschen machen Fehler. Menschen können bösartig sein. Menschen sind manipulierbar.
Uns bleibt die eine Erkenntnis: Nur die Wissenschaft und weitere Forschungsanstrengungen können den Menschen vor dem Menschen schützen.